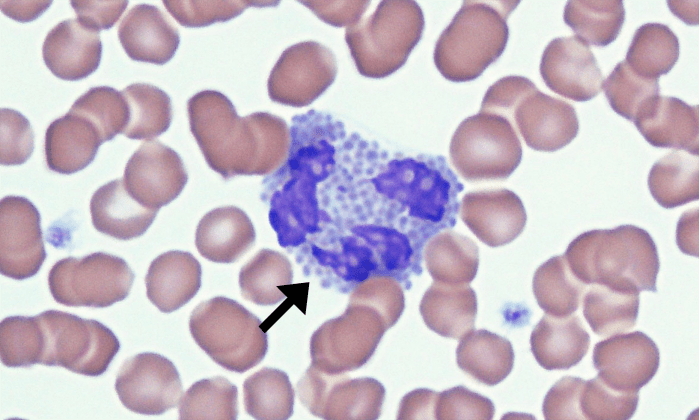
Basophils 3 (Feline 1) ARROWS

Basophils
Morphology: granulocyte with a large irregularly lobulated nucleus, lavender-staining cytoplasm, and numerous purple (basophilic) cytoplasmic granules. Considerable species variation in appearance of basophils.
Look alike: mast cells, other granulocytes (neutrophils, eosinophils)
Clinical relevance: basophils are rare in the blood of healthy animals. Basophilia (↑ basophils in peripheral blood) is usually associated with allergies/hypersensitivities or parasitic infections and is often accompanied by eosinophilia.


